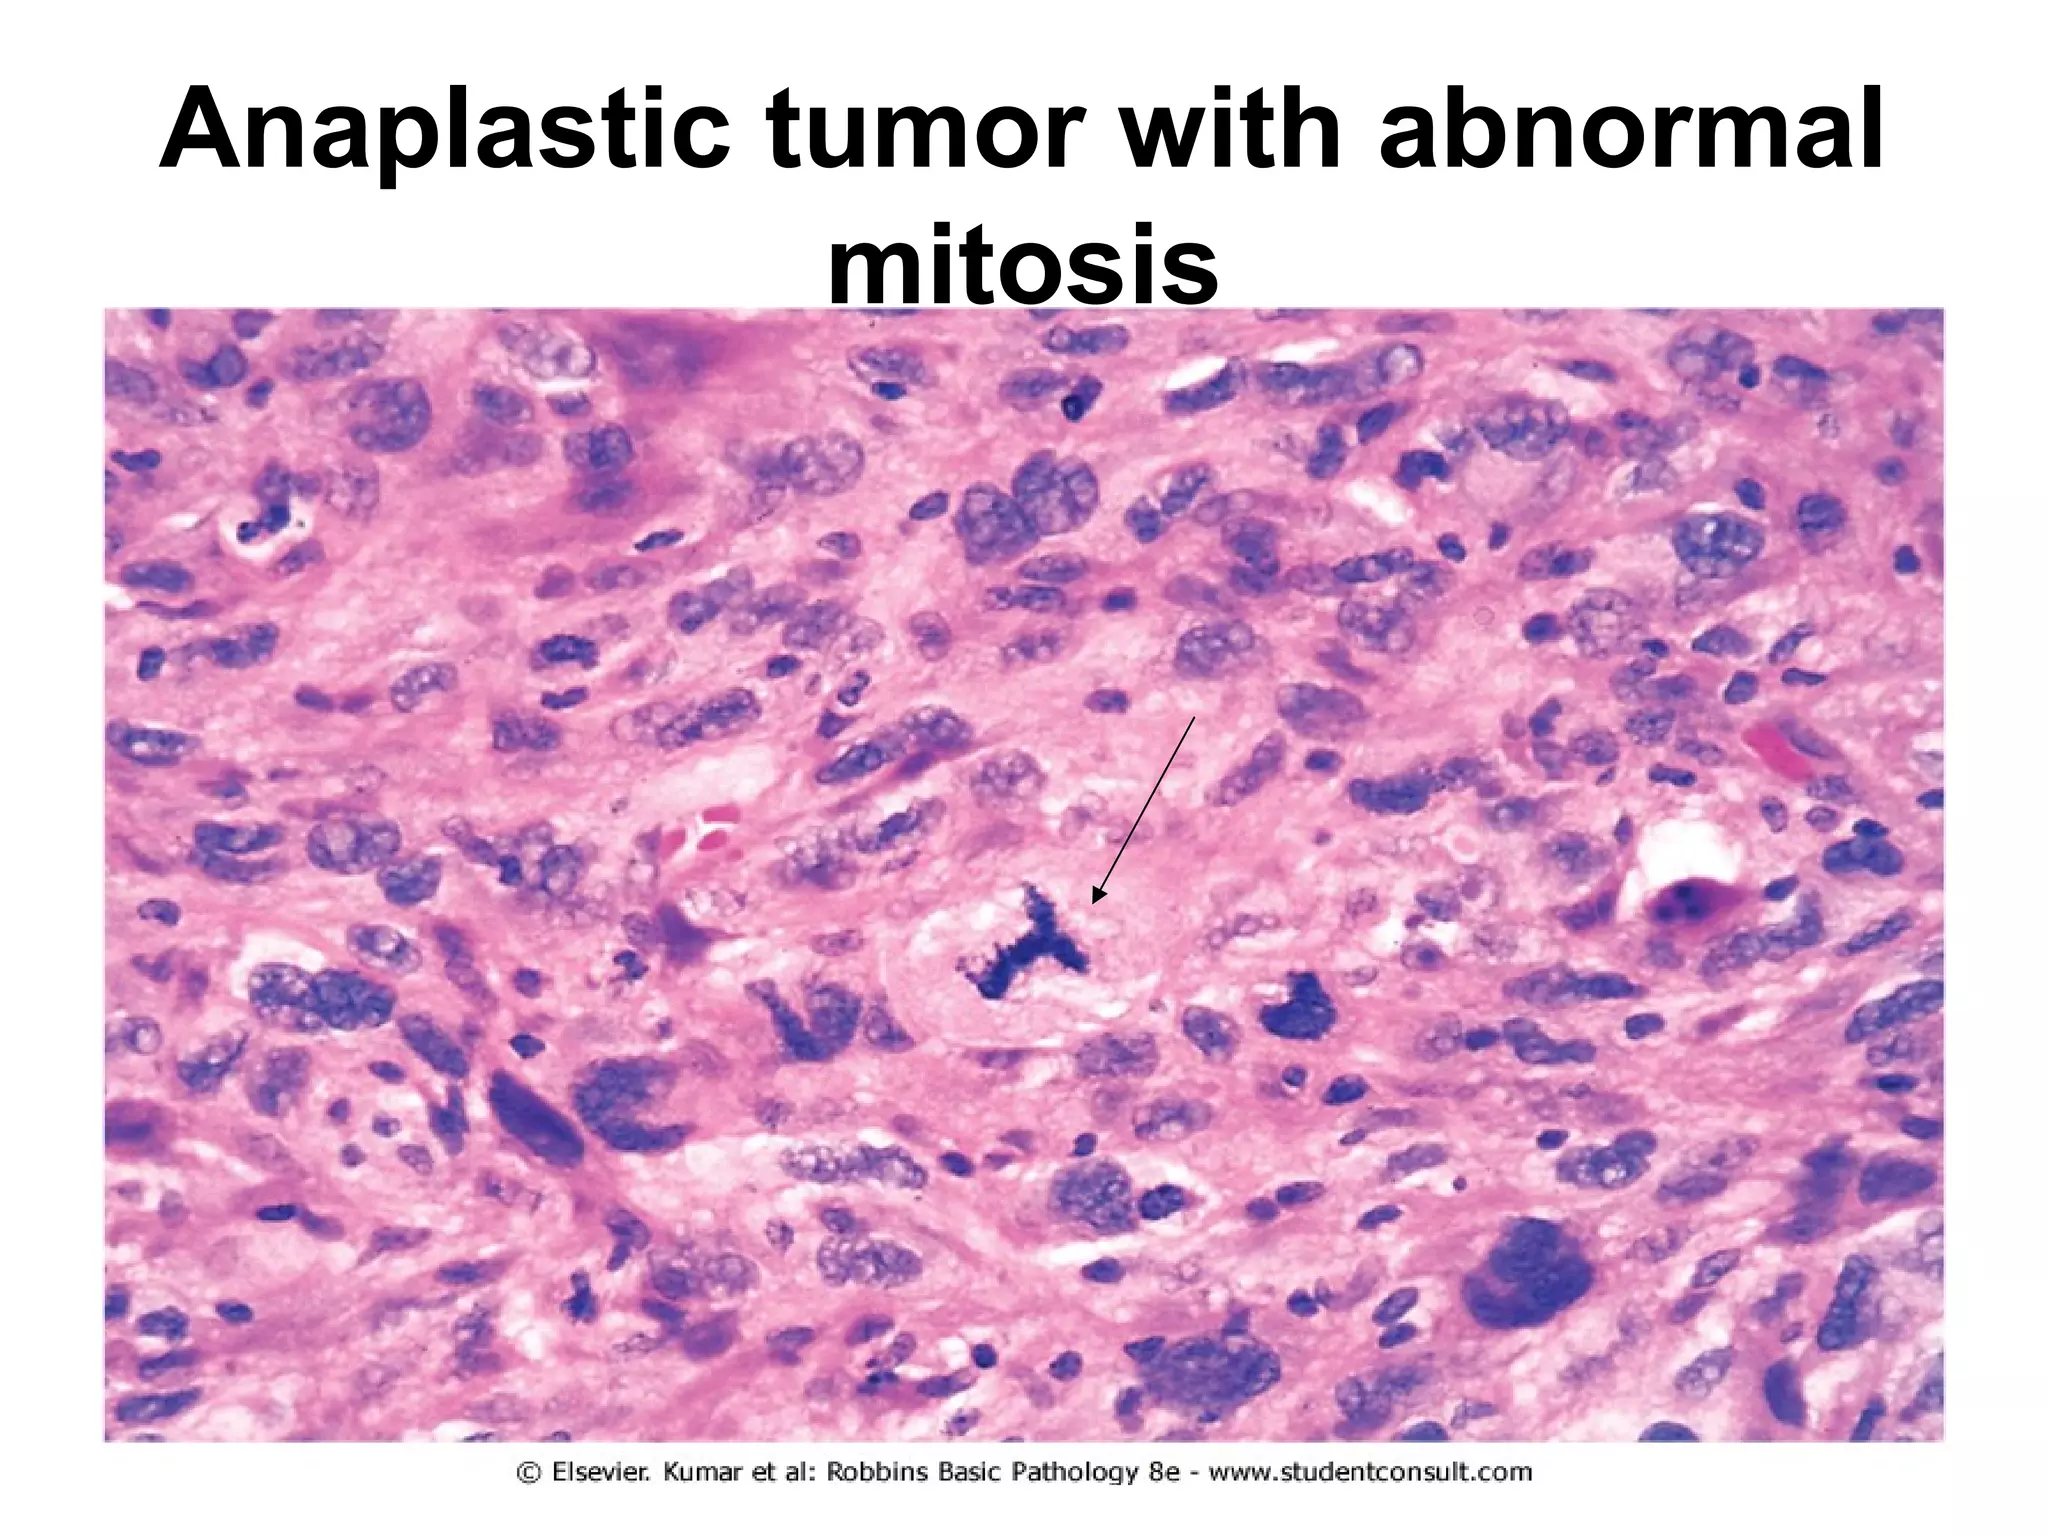
Pleomorphic adenoma

This document contains numerous pathology slides and descriptions of different types of cell and tissue changes seen microscopically. Some key points summarized:
1) Slides show examples of necrosis, inflammation, repair processes like granulation tissue and scarring, and various neoplastic conditions including benign tumors like lipomas and malignant tumors with areas of necrosis, abnormal mitosis, and anaplasia.
2) Specific examples include liver necrosis showing pale hepatocytes without nuclei, acute bronchopneumonia with neutrophils filling alveoli, and granulation tissue forming during repair.
3) Benign tumors discussed include pleomorphic adenomas, fibroadenomas, and mature teratomas, while malignant tumors shown